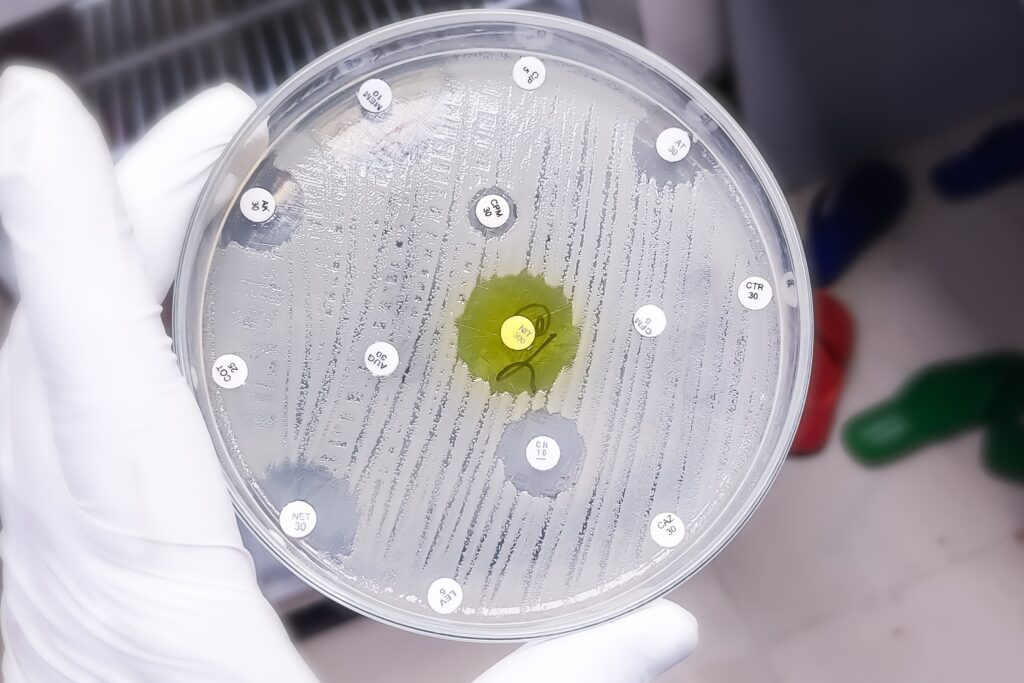

Was wir machen

Hygiene
Nosokomiale Infektionen gefährden nicht nur Patienten, sie kosten Krankenhäusern auch viel Geld.
Im Rahmen unserer Betreuung führen wir Beobachtungen und Begehungen durch. Dadurch lassen sich Schwachstellen bei Prozessen und Verhalten identifizieren. Die sog. Surveillance ist ein wichtiges Werkzeug, um Mängel in OP, Allgemein- und Intensivstation aufzudecken.
Antibiotikamanagement
Antibiotika werden im Krankenhaus häufig eingesetzt, um die Komplikationen medizinischer Behandlungen zu beherrschen.
Im Rahmen unserer Betreuung beraten wir Sie im Einzelfall bei der Interpretation von Befunden, um Antibiotika nur dann einzusetzen, wenn sie unbedingt erforderlich sind. Wir unterstützen Sie bei der Erstellung einer Hausliste und bei der Bewertung der Antibiotikaverbrauchsstatistik und der Keim- und Resistenzstatistik.

Infektionsprävention
Mängel im Verhalten des Personals und Fehler bei der Festlegung von Prozessen können zu Infektionen bei Patienten führen.
Die Beratung und Unterstützung des Personals der Hygieneabteilung im Krankenhaus bei ihrer Arbeit ist wesentliche Aufgabe der Betreuung. Darüber hinaus kann die Schulung von Personal im Umgang mit Laborbefunden und dem korrekten Hygieneverhalten einen wichtigen Beitrag zur Infektionsprävention leisten.
Haben wir Ihr Interesse geweckt?
In einem persönlichen Gespräch lassen wir Ihnen gerne weitere Informationen zukommen.